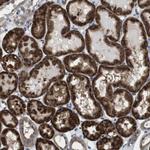
Cdc34 Antibody in Immunohistochemistry (Paraffin) (IHC (P))

Search
Invitrogen
Cdc34 Polyclonal Antibody
{{$productOrderCtrl.translations['antibody.pdp.commerceCard.promotion.promotions']}}
{{$productOrderCtrl.translations['antibody.pdp.commerceCard.promotion.viewpromo']}}
{{$productOrderCtrl.translations['antibody.pdp.commerceCard.promotion.promocode']}}: {{promo.promoCode}} {{promo.promoTitle}} {{promo.promoDescription}}. {{$productOrderCtrl.translations['antibody.pdp.commerceCard.promotion.learnmore']}}

Please note: We are reviewing Western blot images included in the antibody testing data in our catalog, including those provided by third parties. Unless expressly labeled or annotated as “raw-unedited”, Western blot images included in the antibody testing data in our catalog may have been edited, optimized or otherwise adjusted for presentation.
产品信息
PA5-82016
种属反应
宿主/亚型
分类
类型
抗原
偶联物
形式
浓度
规格
纯化类型
保存液
内含物
保存条件
运输条件
RRID
产品详细信息
Immunogen sequence: LNEPNTFSPA NVDASVMYRK WKESKGKDRE YTDIIRKQVL GTKVDAERDG VKVPTTLAEY CVKTKAPAPD EGSDLFYDDY YEDGEVEEEA DSCFGDDEDD SGT
Highest antigen sequence indentity to the following orthologs: Mouse - 98%, Rat - 98%.
靶标信息
Accepts ubiquitin from the E1 complex and catalyzes its covalent attachment to other proteins. In vitro catalyzes 'Lys-48'-linked polyubiquitination. Cooperates with the E2 UBCH5C and the SCF (FBXW11) E3 ligase complex for the polyubiquitination of NFKBIA leading to its subsequent proteasomal degradation. Performs ubiquitin chain elongation building ubiquitin chains from the UBE2D3-primed NFKBIA-linked ubiquitin. UBE2D3 acts as an initiator E2, priming the phosphorylated NFKBIA target at positions 'Lys-21' and/or 'Lys-22' with a monoubiquitin. Cooperates with the SCF (SKP2) E3 ligase complex to regulate cell proliferation through ubiquitination and degradation of MYBL2 and KIP1. Involved in ubiquitin conjugation and degradation of CREM isoform ICERIIgamma and ATF15 resulting in abrogation of ICERIIgamma- and ATF5-mediated repression of cAMP-induced transcription during both meiotic and mitotic cell cycles. Involved in the regulation of the cell cycle G2/M phase through its targeting of the WEE1 kinase for ubiquitination and degradation. Also involved in the degradation of beta-catenin. Is target of human herpes virus 1 protein ICP0, leading to ICP0-dependent dynamic interaction with proteasomes.
仅用于科研。不用于诊断过程。未经明确授权不得转售。
篇参考文献 (0)
生物信息学
蛋白别名: (E3-independent) E2 ubiquitin-conjugating enzyme R1; E2 ubiquitin-conjugating enzyme R1; Ubiquitin-conjugating enzyme E2 R1; Ubiquitin-conjugating enzyme E2-32 kDa complementing; Ubiquitin-conjugating enzyme E2-CDC34; Ubiquitin-protein ligase R1
基因别名: CDC34; UBCH3; UBE2R1
Entrez Gene ID: (Human) 997




